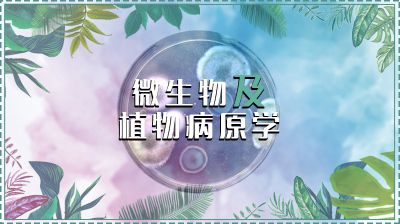

-
- 智慧树在线客服
- 服务时间:8:30-24:00
-
- 400-829-3579
- 服务时间:8:30-24:00
-
- 帮助
微生物泛指一切肉眼看不见或者看不清楚的微小生物的总称,几乎无处不在地存在我们周围。微生物数量巨大,种类多,包括原核生物中的细菌和古细菌,真核生物中的菌物、单细胞藻类和原生动物,以及非细胞生物病毒、朊病毒等。微生物与我们人类关系密切,很多微生物在我们的日常生活、粮食生产、能源加工、医药化工等等许多领域发挥重要作用,可以分离、提取药物分子,用于治疗疾病。对微生物的研究极大地促进了我们对生命科学的研究进展,有多项微生物有关的研究荣膺诺贝尔奖。但有些微生物引起人类、动植物重要疾病等,有些会严重损害水稻、玉米、小麦等农作物的健康生长和安全生产,造成严重经济损失。引起植物病害的微生物称为植物病原物。通过本课程,我们将较为全面地了解、学习和研究微生物及植物病原物的概念、形态、结构、分类鉴定及与植物病害的关系,最大程度地利用微生物促进人类社会和整个生态系统的健康、良性发展和循环。本课程主要参考教材是《植物病原微生物学》(张国珍主编,中国农业大学出版社,2017年)。
累计选课
人
选课学校
所
公众学习者所属学校
所
累计互动
次
了解更多
老师您好!感谢您对本课的认可,请准确填写您的个人信息,
我们的运行服务专员会跟您联系,沟通选课事宜。
提交成功
我们的运行服务专员会在1-3个工作日内同您进行电话沟通,请保持手机畅通
请选择您的使用目的
该门课程当前学期未运行哦~
如您是为了自我提升请选择下方【去学习】按钮;如无【去学习】按钮则说明老师并未发布该课程的公开课,请选择其他课程
您当前身份为学生,仅老师可提交共享课选课申请。
该门课程未发布公开课,请选择其他课程~
该门课程为资源库课程,请去学堂选择【资源库课程】~
您当前选中的课程